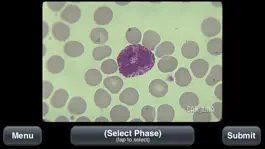
Game screenshot Animal Histology hack

Animal Histology Взлом 3.1 + Чит Коды
Разработчик: Carolina Biological Supply
Категория: Образование
Цена: Бесплатно
Версия: 3.1
ID: com.carolina.animalHistology
Скриншоты

Описание
The Animal Histology app features images from some of Carolina’s best microscope slides, including mitosis in fish embryo and detailed vertebrate histology. The histology photos cover main variations of the four basic tissue types. Text describes the tissues' functions and locations. Because this reference app includes interactive practice sections, it serves in quick review as well as initial learning. The Lite version is free and addresses only mitosis.
История обновлений
3.1
2016-03-04
This app has been updated by Apple to display the Apple Watch app icon.
**iOS 9 Compatibility
**Minor Bug Fixes
**iOS 9 Compatibility
**Minor Bug Fixes
3.0
2015-01-18
**iOS 8 Compatibility
2.1
2013-10-15
**iOS 7 Compatibility and Bug Fixes
2.0
2012-10-25
**Updated for iPhone 5
**Updated for the new iPad
**New Graphics Design
**Updated for the new iPad
**New Graphics Design
1.1
2012-10-09
**iOS 6 compatibility
1.0
2011-09-06
Способы взлома Animal Histology
- Промо коды и коды погашений (Получить коды)
Скачать взломанный APK файл
Скачать Animal Histology MOD APK
Запросить взлом




